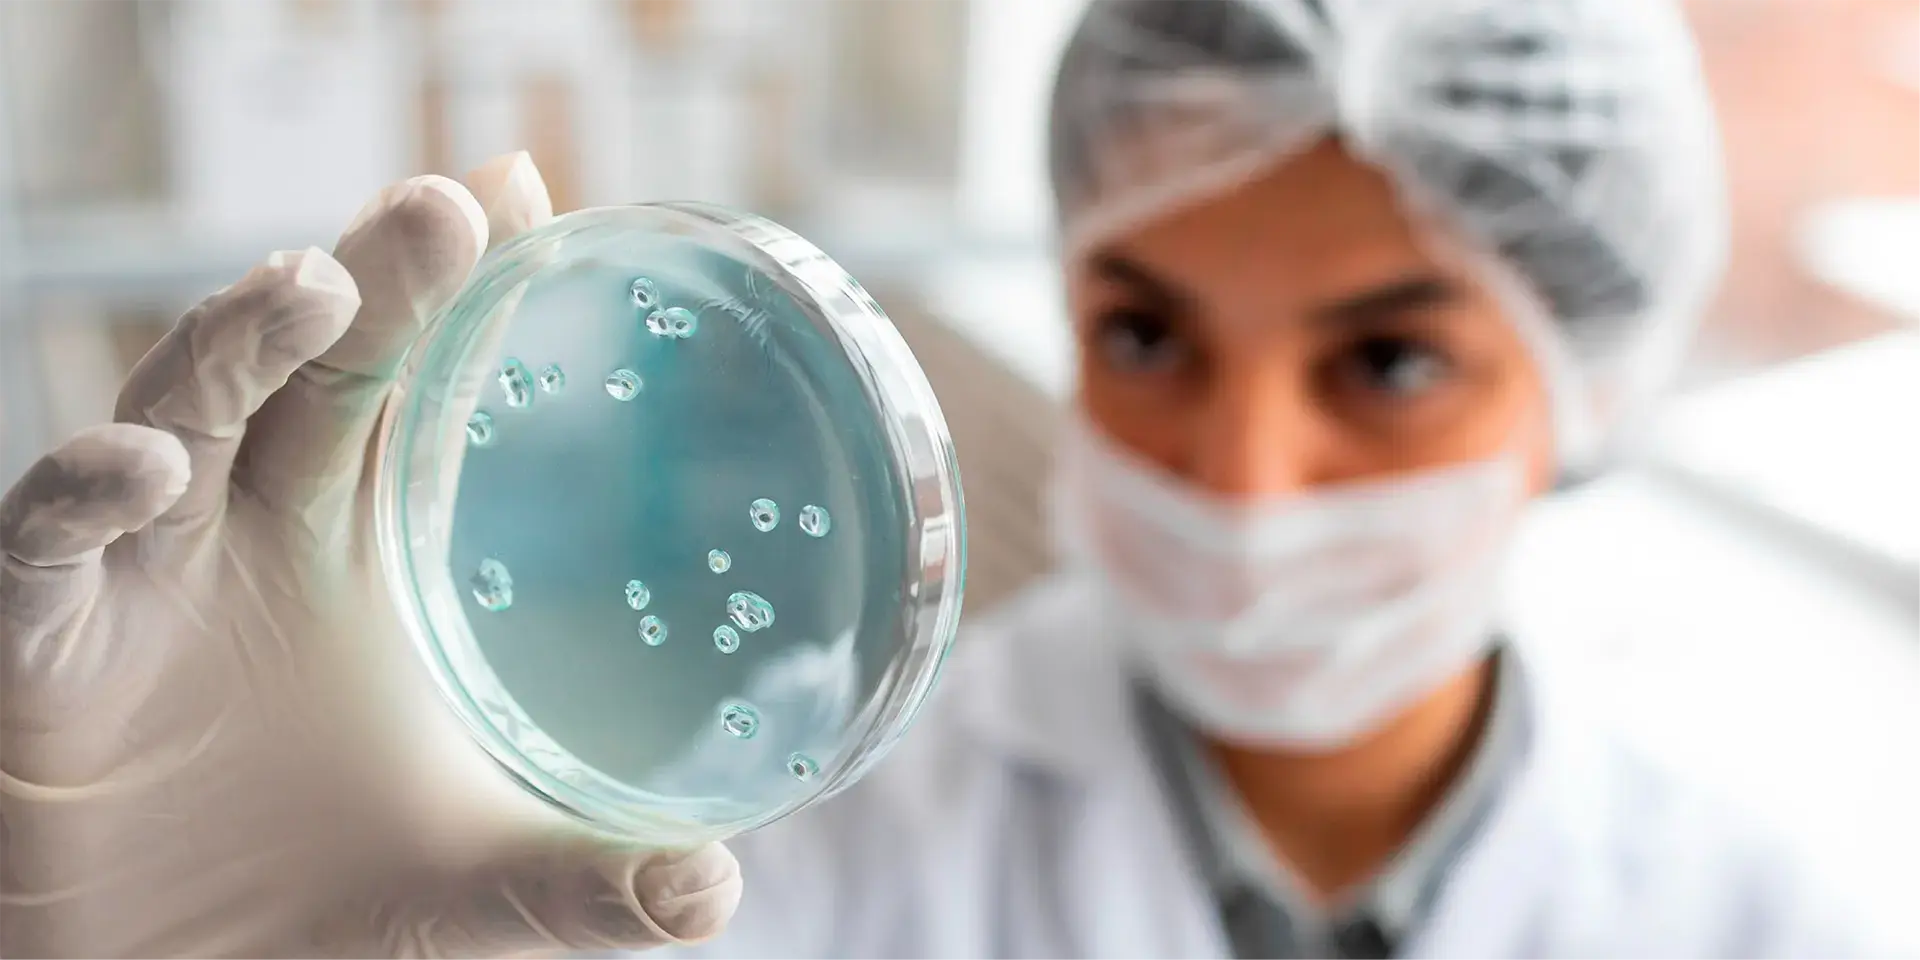
Portada Efemerides 2025 30 Enero 2

Día Mundial de las Enfermedades Tropicales Desatendidas
Por: Subdirección de Educación Continua del Área de la Salud
Las enfermedades tropicales desatendidas (ETD) son un conjunto de aproximadamente 20 afecciones que prevalecen principalmente en las regiones más pobres del mundo, donde el acceso a agua potable, saneamiento básico y atención médica es limitado o inexistente.

Fuente: Freepik
Estas enfermedades, causadas por diversos patógenos como virus, bacterias, parásitos, hongos y toxinas, incluyen la leishmaniasis, la lepra, la filariasis linfática y la enfermedad de Chagas, entre otras.
En México, la Comisión Federal para la Protección contra Riesgos Sanitarios (Cofepris) ha implementado planes de acción para abordar las ETD, reconociendo que afectan principalmente a las poblaciones más pobres y que cuentan con opciones limitadas de servicios de salud.
Además, estados como Chiapas han avanzado en el control de estas enfermedades, especialmente en la reducción de la incidencia de dengue y paludismo.
Importancia del conocimiento de las ETD
Comprender y difundir información sobre las ETD es crucial por varias razones:
- Impacto en la Salud Pública: Las ETD pueden causar discapacidades permanentes, afectando el crecimiento, el desarrollo físico e intelectual y la capacidad de aprendizaje, lo que disminuye la productividad laboral y, por ende, la capacidad de generar ingresos adecuados.
- Ciclo de pobreza: Estas enfermedades perpetúan un ciclo de resultados educativos deficientes y oportunidades profesionales limitadas, además de estar asociadas a la estigmatización y la exclusión social.
- Desafíos económicos: Las ETD imponen una carga económica significativa tanto a las personas afectadas como a los sistemas de salud, especialmente en comunidades con recursos limitados.
Propuestas de acción
Para enfrentar eficazmente las ETD, se proponen las siguientes acciones:
- Fortalecimiento de programas de prevención y control: implementar estrategias integrales que incluyan campañas de vacunación, control de vectores y mejora del saneamiento básico.
- Educación y sensibilización comunitaria: desarrollar programas educativos que informen a las comunidades sobre las ETD, sus modos de transmisión y medidas preventivas.
- Investigación y desarrollo: fomentar la investigación para el desarrollo de nuevos tratamientos y diagnósticos, adaptados a las necesidades locales y accesibles para las poblaciones afectadas.
- Colaboración internacional y nacional: fortalecer las alianzas entre gobiernos, organizaciones internacionales y la sociedad civil para coordinar esfuerzos y compartir recursos en la lucha contra las ETD.
- Inversión en infraestructura sanitaria: mejorar el acceso a servicios de salud de calidad, agua potable y saneamiento, fundamentales para la prevención y control de estas enfermedades.

Fuente: Freepik
Abordar las enfermedades tropicales desatendidas requiere un compromiso sostenido y acciones coordinadas que promuevan la equidad en salud y mejoren la calidad de vida de las poblaciones más vulnerables.
Referencias:
- Organización Panamericana de la Salud (2024). Día Mundial de las Enfermedades Tropicales Desatendidas 2024. Recuperado el 20 de enero de 2025, de https://www.paho.org/es/campanas/dia-mundial-enfermedades-tropicales-desatendidas-2024
- Organización Panamericana de la Salud (s.f.) Enfermedades desatendidas, tropicales y transmitidas por vectores. Recuperado el 20 de enero de 2025, de https://www.paho.org/es/temas/enfermedades-desatendidas-tropicales-transmitidas-por-vectores
- Comisión Federal para la Protección contra Riesgos Sanitarios y Gobierno de México (2021) Cofepris lanza plan de acción para atender enfermedades tropicales desatendidas. Recuperado el 20 de enero de 2025, de https://www.gob.mx/cofepris/es/articulos/cofepris-lanza-plan-de-accion-para-atender-enfermedades-tropicales-desatendidas
- Secretaría de Salud Chiapas (2024) Chiapas avanza en el control de las enfermedades tropicales desatendidas. Recuperado el 20 de enero de 2025, de https://saludchiapas.gob.mx/noticias/post/chiapas-avanza-en-el-control-de-las-enfermedades-tropicales-desatendidas
- Organización Mundial de la Salud (2025) Enfermedades tropicales desatendidas. Recuperado el 20 de enero de 2025, de https://www.who.int/es/news-room/questions-and-answers/item/neglected-tropical-diseases

Fuente: Freepik